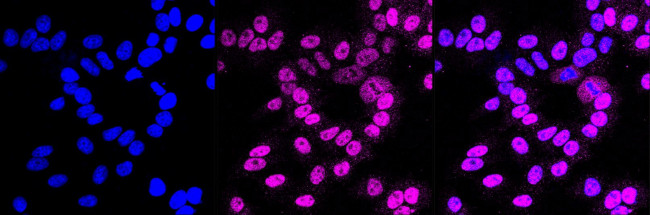
ETS1 Antibody in Immunocytochemistry (ICC/IF)

Search
Invitrogen
ETS1 Recombinant Rabbit Monoclonal Antibody (23GB1160)
{{$productOrderCtrl.translations['antibody.pdp.commerceCard.promotion.promotions']}}
{{$productOrderCtrl.translations['antibody.pdp.commerceCard.promotion.viewpromo']}}
{{$productOrderCtrl.translations['antibody.pdp.commerceCard.promotion.promocode']}}: {{promo.promoCode}} {{promo.promoTitle}} {{promo.promoDescription}}. {{$productOrderCtrl.translations['antibody.pdp.commerceCard.promotion.learnmore']}}
图: 1 / 3
ETS1 Antibody (MA5-53120) in ICC/IF



Please note: We are reviewing Western blot images included in the antibody testing data in our catalog, including those provided by third parties. Unless expressly labeled or annotated as “raw-unedited”, Western blot images included in the antibody testing data in our catalog may have been edited, optimized or otherwise adjusted for presentation.
产品信息
MA5-53120
种属反应
宿主/亚型
Expression System
分类
类型
克隆号
抗原
偶联物
形式
纯化类型
保存液
内含物
保存条件
运输条件
RRID
靶标信息
ETS1 (c-Ets-1; v-ets erythroblastosis virus E26 oncogene homlog 1 (avian); ETS-1; EWSR2; p54), a 441 A. A protein, is a member of DNA-binding ETS protein family. It is a multifunctional protein consisting of an N-terminal pointed domain, a central transactivation domain and 2 auto inhibitory domains flanked on both sides of conserved C-terminal Ets domain. It interacts with factors including PEBP2alphaA, p300/CBP and mediates transactivation of Osteopontin, Presenilin-1, Stromelysin and Collagenase. It is activated by Ras/MAPK signaling and its expression is up-regulated in resting T-cells. Its activity is modulated by various factors including AP-1, Sp-1, c-myb and MafB. Sp100 activates ETS1 in nuclear bodies. It interacts with EAP1/Daxx and causes repression of MMP1 and BCL2 transactivation. It interacts with STAT6 and modulates Socs-1 expression induced by IL-4. It interacts with GATA3 and positively regulates Tax-1 dependent IL-5 expression.
仅用于科研。不用于诊断过程。未经明确授权不得转售。
篇参考文献 (0)
生物信息学
蛋白别名: ets protein; Ets-1Delta(III-VI); FLJ10768; p54; Protein C-ets-1
基因别名: ETS1; EWSR2
Entrez Gene ID: (Human) 2113